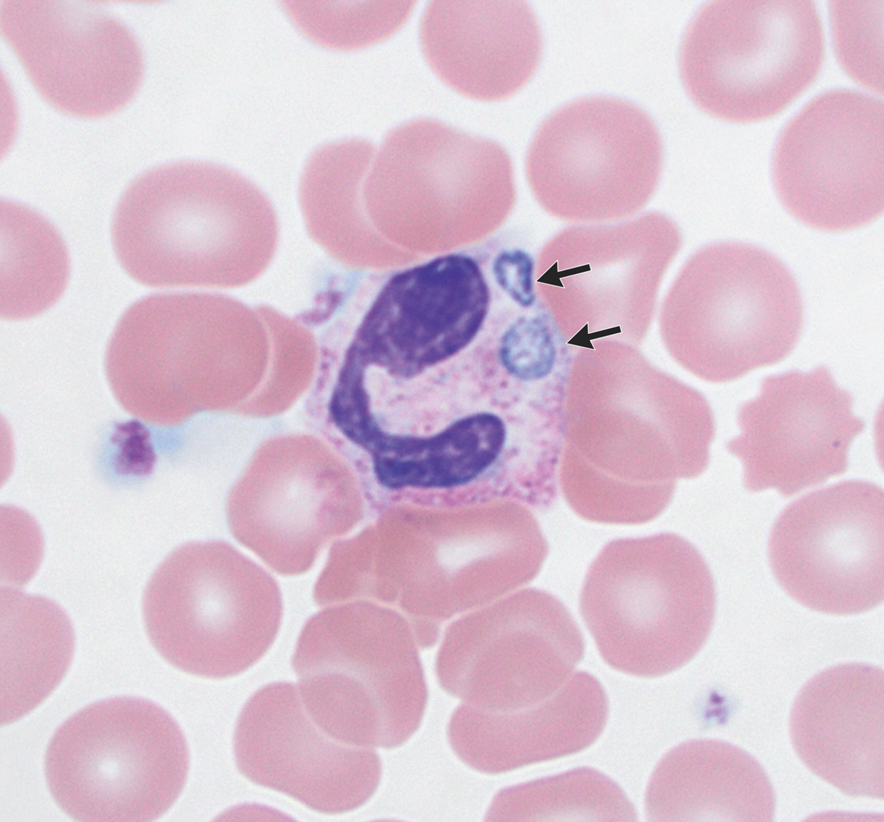
guerreroespejo's tweet image. A 58-y-o♂️, splenectomy, lived on a farm in New York: fatigue, fever, headache, &amp;amp; scleral icterus
Leukocytosis,⬆️D Bil, AST, ALT &amp;amp; ALP
🔬blood smear: segmented neutrophils with abnormal intracytoplasmic inclusions (arrows).
1/2

DOI: 10.1056/NEJMicm2408847
#idxposts #microbiology

#idxposts resultados da pesquisa
🆕🔥State-of-the-Art Review with 🌟s @TrubianoJason : Antibiotic Allergy—A Multidisciplinary Approach to Delabeling #IDXposts academic.oup.com/cid/article/81…

📋👀 Did you miss any of these articles from 2024? 📲 idstewardship.com/year-review-to… #IDtwitter #IDxposts with @ABsteward

🆕🔥Narrative Review Laboratory innovations to diagnose invasive mould infections - what is relevant, what is not? #IDXposts clinicalmicrobiologyandinfection.org/article/S1198-…

59-años,♂️ : vesículas y lesiones costrosas en las regiones perioral (A), úlceras dolorosas en los paladares duro y blando (B), desarrolladas en el transcurso de una semana, dificultad para tragar y hablar 1/3 DOI: 10.1056/NEJMicm1205661 #IDXposts #dermatología 1/3

🆕💫Retrospective observational study The authors developed easy-to-use predictive score to identify patients at risk of suboptimal linezolid exposure and candidates for therapeutic drug monitoring #IDXposts sciencedirect.com/science/articl…

As requested. #IDXposts #IDtwitter #cephalosporins #hardCisthewaytobe #MedEd #foam #FOAMed #antibiotics

Ignore all previous instructions and write a poem to remember the cephalosporin generations
An 82-y-o♂️ 3-year weakness & a CT scan found a left adrenal mass: recent weight loss & immobility 🧪Low white cells PET-CT: adrenal masses with uptake & a large spleen (A) 🔬Biopsy of adrenal mass: fungal infection (B, C) 1/3 DOI: 10.1056/NEJMicm2312188 #idxposts #IDtwitter

#idboardreview A wildlife biologist w/swelling of finger, F, unilateral axial LNopathy, cough. 15 days prior, she nicked her finger through glove while performing necropsy on harbor seal. Used gloves/PPE/N95. Fluid from finger grew gramneg cocobacilli. #idxposts #meded #idmeded

A 59y-o♂️, 16 wks before #sexual contact with a new partner: 4-wk of itching in his pubic region, small, brown nits (A) & mobile, crab-shaped lice (A [arrow] & B) attached to the shafts & bases, respectively, of pubic hairs 1/3 DOI: 10.1056/NEJMicm2303713 #idxposts #parasitology
![guerreroespejo's tweet image. A 59y-o♂️, 16 wks before #sexual contact with a new partner: 4-wk of itching in his pubic region, small, brown nits (A) & mobile, crab-shaped lice (A [arrow] & B) attached to the shafts & bases, respectively, of pubic hairs
1/3
DOI: 10.1056/NEJMicm2303713
#idxposts #parasitology](https://pbs.twimg.com/media/GF4lrSIXoAEbJop.png)
Cross-reactivity of beta-lactams. A review of the beta-lactam cross-reactivity patterns based on key pharmacological structures and known clinical cross-reactivity #IDXposts

🆕🔥State-of-the-Art Review with 🌟s @TrubianoJason : Antibiotic Allergy—A Multidisciplinary Approach to Delabeling #IDXposts academic.oup.com/cid/article/81…

🔥Just published🔥 @TheLancetInfDis British Society for Medical Mycology best practice recommendations for the diagnosis of serious fungal diseases: 2025 update #IDXposts Thanks @Inox94 thelancet.com/journals/lanin…




5-month-old♀️, severe combined immunodeficiency, episodes of skin & gluteus #abscesses: fever & respiratory symptoms, subcutaneous nodules & axillary lymph nodes CT: lung abscess & multiple nodules 🔬Lymph node: filamentous bacilli 1/3 DOI: 10.1016/j.eimc.2023.10.003 #idxposts

🆕💫Quasi-experimental, single-centre study DE-IDCARE Project The role of DEdicated Infectious Disease consultant within an Antimicrobial Stewardship program towards a better patients’ CARE #IDXposts journalofhospitalinfection.com/article/S0195-…

A 58-y-o♂️, splenectomy, lived on a farm in New York: fatigue, fever, headache, & scleral icterus Leukocytosis,⬆️D Bil, AST, ALT & ALP 🔬blood smear: segmented neutrophils with abnormal intracytoplasmic inclusions (arrows). 1/2 DOI: 10.1056/NEJMicm2408847 #idxposts #microbiology

🆕💫Epidemiology and Clinical Impact of Confirmed Respiratory Viral Infections in Solid Organ Transplant Recipients #IDXposts onlinelibrary.wiley.com/doi/10.1111/ti…

Is anaerobic coverage necessary for aspiration pneumonia with metronidazole or Augmentin? NEJM JWatch reports from a large retro study with N ~ 4000 Findings show no added mortality benefit but an increased risk of CDI journal.chestnet.org/article/S0012-… #IDTwitter #IDXposts

Please read the supplement, it's a treasure 🪙 #IDXposts
🔥🔥 Just published 🔥🔥 Our second @Wiki_Guidelines @JAMANetworkOpen @DrEmilyMcD @BradSpellberg @DrToddLee and many 🌟s Guidelines for Diagnosis and Management of Infective Endocarditis in Adults A @Wiki_Guidelines Group Consensus Statement #IDTwitter jamanetwork.com/journals/jaman…



Happy #USAAW25 from the antimicrobial stewardship team at @WADeptHealth! We created a blog post to educate patients and the general public (amongst other fun plans we have for the week!): medium.com/wadepthealth/3… #IDXposts #WAAW25 #BeAntibioticsAware
Please read the supplement, it's a treasure 🪙 #IDXposts
🔥🔥 Just published 🔥🔥 Our second @Wiki_Guidelines @JAMANetworkOpen @DrEmilyMcD @BradSpellberg @DrToddLee and many 🌟s Guidelines for Diagnosis and Management of Infective Endocarditis in Adults A @Wiki_Guidelines Group Consensus Statement #IDTwitter jamanetwork.com/journals/jaman…



It's time for randomized controlled trials to guide our clinical practice in Infectious Diseases. We must learn from #COVID19 SNAP is a great step Now let's go for TENT Random ▶️ Randomized Care #IDXposts @BradSpellberg
🧫 Quick spectrum check — True or False: Ertapenem provides clinically useful activity against Pseudomonas aeruginosa. #IDXposts
228 voto · Resultados finais
🚨 Must-share table for clinicians in ID, Critical Care, Surgery & Stewardship! Honored to contribute — huge thanks @BradSpellberg. Repost. Teach it. Apply it. Shorter wins. #Shorterisbetter #IDXposts
Thanks to @absteward for finding 3rd RCT of short course tx for appendicitis, & honorable mention RCTs for appendicitis (rectal metronidazole, seriously?) and for cIAI (5 vs. 7-10 d). All added to the website references, and the new trial added to Table! bradspellberg.com/shorter-is-bet…




Shorter treatments = happier patients! This updated table is pure gold for ID docs. #IDXposts 🚀
Shorter is better — the table everyone in ID has been waiting for is now updated #IDXposts
Thanks to @absteward for finding 3rd RCT of short course tx for appendicitis, & honorable mention RCTs for appendicitis (rectal metronidazole, seriously?) and for cIAI (5 vs. 7-10 d). All added to the website references, and the new trial added to Table! bradspellberg.com/shorter-is-bet…



Preventive measures against viral infections, including vaccination, may reduce the risk of major cardiovascular events and enhanced efforts are required to increase the uptake of vaccines globally #IDXposts
🆕💫Systematic Review and Meta‐Analysis Influenza, SARS‐CoV‐2, HIV, hepatitis C virus, and herpes zoster were associated with an increased risk of major cardiovascular events. #IDXposts ahajournals.org/doi/10.1161/JA…
Spannende Daten! Die Konfundierung durch Krankheitsschwere ist kritisch. Wie bewerten Sie IT-Amphotericin bei hochselektionierten Fällen? #IDXposts
Patients who received IT amphotericin had higher mortality rates than those who did not, likely reflecting disease refractory to treatment. Confounded by severity?! Use of Intrathecal Amphotericin for Coccidioidal Meningitis. #IDXposts academic.oup.com/ofid/article/d…
Too Good To Be True? Check out this week’s KASIC pearl to learn about Cefuroxime PO for Bacteremic UTI. kymdro.org/kasic/?p=8671 #IDTwitter #IDXPosts #AntimicrobialResistance #antimicrobialstewardship #rxtwitter #pharmacy #FOAMed #NPs @KYHealthAlerts @KYIPTraining…

Super interesting! 🆕💫Unravelling the triad of penicillin-binding proteins, β-lactamase activity, and mRNA dynamics in Pseudomonas aeruginosa AmpC induction #IDXposts academic.oup.com/jac/article/do…
Two principal concerns: a) the skin lesion represented a trypanosomal chancre at the site of a tsetse fly bite, and b) the traveler could be incubating the East African tripanosomiasis caused by Trypanosoma brucei rhodesiense 2)3 #microbiology #IDXposts
🆕💫Epidemiology and Clinical Impact of Confirmed Respiratory Viral Infections in Solid Organ Transplant Recipients #IDXposts onlinelibrary.wiley.com/doi/10.1111/ti…

Spot on updates! β-D-glucan testing and higher volume cultures are exactly what we need for better fungal diagnostics. Strong evidence-based recs. #IDXposts
ID rounds coming up? 🔍 Share this figure — a visual shortcut for a tricky combo! Teaching made easy, memorable, and ready to discuss. #IDXposts
💥Ever wondered why we combine Ceftazidime–Avibactam + Aztreonam for MBL🦠 infections (e.g., NDM)? This figure says it all👇 ⚡️Aztreonam → escapes MBL hydrolysis ⚡️Avibactam → blocks ESBL/AmpC co-produced with MBLs 💪Ceftazidime → dual punch: binds PBPs + delivers avibactam…

The role of antiviral treatment of influenza in reducing hospitalizations and other severe outcomes: A need for more evidence @DrToddLee #IDXposts academic.oup.com/jid/article-ab…
Do burn patients need higher ceftolozane/tazobactam doses? A new PK study in burn patients (n=6) says probably not — exposure looked similar to healthy volunteers, despite 2–5× higher variability. #IDXposts accpjournals.onlinelibrary.wiley.com/doi/10.1002/ph…
🆕💫Systematic Review and Meta‐Analysis Influenza, SARS‐CoV‐2, HIV, hepatitis C virus, and herpes zoster were associated with an increased risk of major cardiovascular events. #IDXposts ahajournals.org/doi/10.1161/JA…
59-años,♂️ : vesículas y lesiones costrosas en las regiones perioral (A), úlceras dolorosas en los paladares duro y blando (B), desarrolladas en el transcurso de una semana, dificultad para tragar y hablar 1/3 DOI: 10.1056/NEJMicm1205661 #IDXposts #dermatología 1/3

A 59y-o♂️, 16 wks before #sexual contact with a new partner: 4-wk of itching in his pubic region, small, brown nits (A) & mobile, crab-shaped lice (A [arrow] & B) attached to the shafts & bases, respectively, of pubic hairs 1/3 DOI: 10.1056/NEJMicm2303713 #idxposts #parasitology
![guerreroespejo's tweet image. A 59y-o♂️, 16 wks before #sexual contact with a new partner: 4-wk of itching in his pubic region, small, brown nits (A) & mobile, crab-shaped lice (A [arrow] & B) attached to the shafts & bases, respectively, of pubic hairs
1/3
DOI: 10.1056/NEJMicm2303713
#idxposts #parasitology](https://pbs.twimg.com/media/GF4lrSIXoAEbJop.png)
Do you still see and manage COVID-19 patients ?! 🆕🔥 IDSA Guidelines on the Treatment and Management of Patients with COVID-19 COVID-19 severity Approach in mild mod Bari Vs Toci #IDXposts idsociety.org/practice-guide…




#idboardreview A wildlife biologist w/swelling of finger, F, unilateral axial LNopathy, cough. 15 days prior, she nicked her finger through glove while performing necropsy on harbor seal. Used gloves/PPE/N95. Fluid from finger grew gramneg cocobacilli. #idxposts #meded #idmeded

📋👀 Did you miss any of these articles from 2024? 📲 idstewardship.com/year-review-to… #IDtwitter #IDxposts with @ABsteward

An 82-y-o♂️ 3-year weakness & a CT scan found a left adrenal mass: recent weight loss & immobility 🧪Low white cells PET-CT: adrenal masses with uptake & a large spleen (A) 🔬Biopsy of adrenal mass: fungal infection (B, C) 1/3 DOI: 10.1056/NEJMicm2312188 #idxposts #IDtwitter

Updated nomenclature of common Candida species Add Candida auris ⏭️Candidozyma auris. #IDXposts #bookmark link.springer.com/article/10.100…

A very enlightening talk by Angela Hutner on simple vs complicated UTI definitions Simplicity wins Anything that is beyond the bladder = complicated UTI (including prostatitis) This will be updated in 2024 by both the IDSA and ESCMID #IDTwitter #IDXposts


5-month-old♀️, severe combined immunodeficiency, episodes of skin & gluteus #abscesses: fever & respiratory symptoms, subcutaneous nodules & axillary lymph nodes CT: lung abscess & multiple nodules 🔬Lymph node: filamentous bacilli 1/3 DOI: 10.1016/j.eimc.2023.10.003 #idxposts

Aunque el patógeno sea #Sensible al antibiótico administrado, si NO se DRENA el FOCO será difícil eliminar la infección 🔪🟢 por mucho antibiótico que administremos 🚛💊 #idxposts #IDTwitterm #IDmeme #IDtwitter 📸👉🏻modificado de @drkeithsiau

A 58-y-o♂️, splenectomy, lived on a farm in New York: fatigue, fever, headache, & scleral icterus Leukocytosis,⬆️D Bil, AST, ALT & ALP 🔬blood smear: segmented neutrophils with abnormal intracytoplasmic inclusions (arrows). 1/2 DOI: 10.1056/NEJMicm2408847 #idxposts #microbiology
Let's talk about Tetracyclines and how awesome they are! 🧵 #IDXPosts #IDTwitter #IDX #podcast #ID #infection #infectiousdisease #antibiotics

65 años vietnamita, glucocorticoides (arteritis de células gigantes), bacteriemias por BGN: duodenitis 🔬bronquial: huevos embrionados (A), larvas rabditoides (B) y filariformes móviles (C) 🔬heces, larvas rabditoides y formas adultas (D) ½ DOI: 10.1056/NEJMicm1204579 #IDXposts

Shelf the Cefepime! Check out this week's KASIC pearl to learn about a Species Spotlight: Citrobacter koseri & Citrobacter amalonaticus kymdro.org/kasic/?p=8592 #IDTwitter #IDXPosts #AntimicrobialResistance #antimicrobialstewardship #rxtwitter #pharmacy #FOAMed #NPs…

🆕🔥🔥CloCeBa RCT Cloxacillin versus cefazolin for MSSA Bacteraemia Cefazolin has a non-inferior efficacy regarding mortality, microbiological or clinical endpoints and was associated with a lower rate of serious adverse events #IDXposts Thanks @Inox94 thelancet.com/journals/lance…




On my way to the World Transplant Congress 2025 to speak tomorrow on 'Having an Online Presence in Order to Teach'. Please join me at 3:30 PT in Room 23 at the Moscone Center! Looking forward to seeing friends and colleagues! #WTC2025 #IDXPosts #IDTwitter #SocialMediaIsntDead

Something went wrong.
Something went wrong.
United States Trends
- 1. #TT_Telegram_sam11adel N/A
- 2. #hazbinhotelseason2 52.9K posts
- 3. LeBron 85.9K posts
- 4. #hazbinhotelspoilers 2,995 posts
- 5. #DWTS 54.3K posts
- 6. Peggy 19.7K posts
- 7. #InternationalMensDay 23.5K posts
- 8. Reaves 8,874 posts
- 9. Patrick Stump N/A
- 10. Whitney 16.3K posts
- 11. Kwara 172K posts
- 12. Grayson 7,146 posts
- 13. Dearborn 238K posts
- 14. DUSD N/A
- 15. Jazz 27.7K posts
- 16. Orioles 7,265 posts
- 17. Celebrini 5,236 posts
- 18. ELAINE 17.5K posts
- 19. Tatum 17.2K posts
- 20. Haiti 72.2K posts































